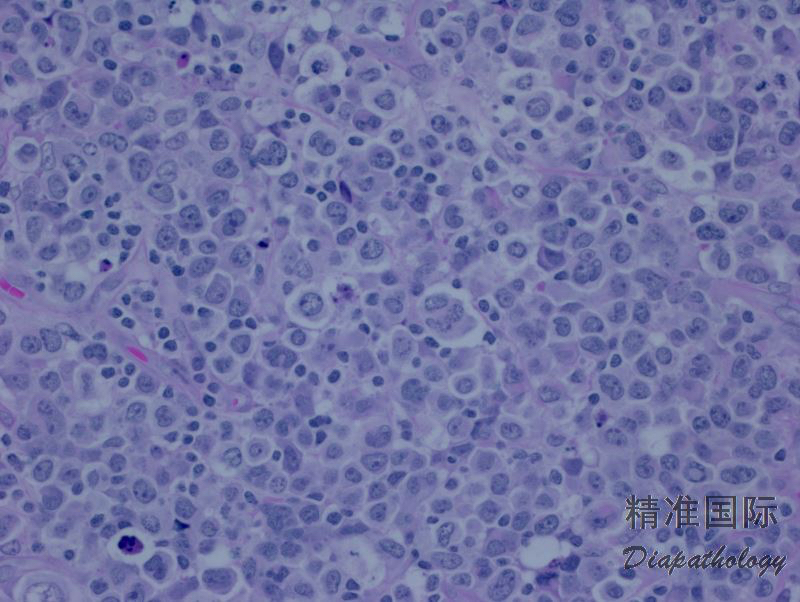
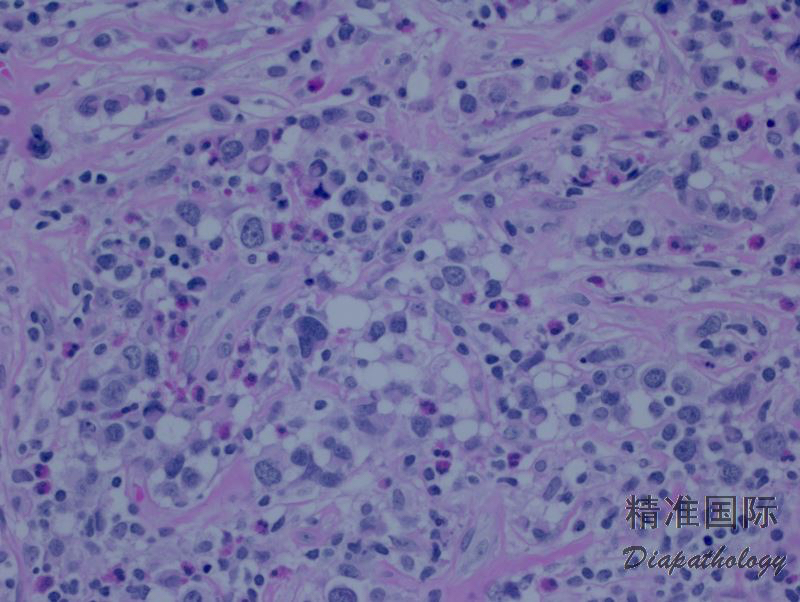
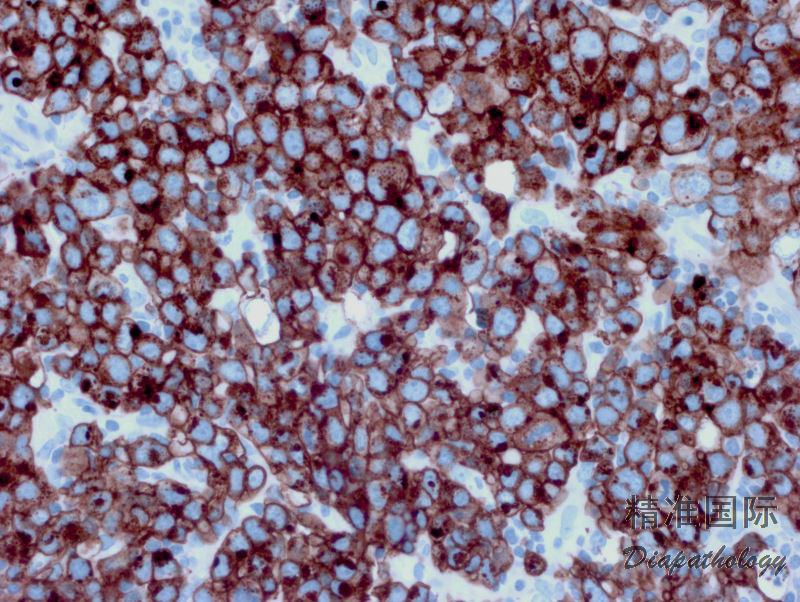

间变大细胞淋巴瘤,ALK 阴性
Anaplastic large cell lymphoma, ALK-negative
概述:
ALK 阴性 ALCL 是一类 CD30 阳性 T 细胞淋巴瘤,其形态学与 ALK 阳性 ALCL 不能区分,不表达 ALK 蛋白,2008WHO 列为临时疾病实体,但 2017 年版 WHO 已将其确立为正式疾病实体。ALK 阴性 ALCL 必需与原发性皮肤 ALCL、霍奇金淋巴瘤及其它具有间变特征或者表达 CD30 的 T 细胞或 B 细胞淋巴瘤亚型相鉴别。
诊断要点:
发病高峰年龄 40-65 岁,表现为进展期疾病,B 症状。主要累及外周淋巴结,也可侵犯结外部位(皮肤、骨、软组织),但较 ALK+ ALCL 少。
肿瘤细胞弥漫增生,常呈粘附性生长和窦内寝润。细胞大小多形,但主要类似普通型 ALK+ ALCL 的细胞形态,且间变性更明显,并存在多少不等的标志性细胞。但不存在小细胞型(或许小细胞为主型与 PTCL-NOS 难以鉴别,归类为后者了)等其它变异型。需注意的是,ALK- ALCL 伴 DUSP22-IRF4 易位的病例,细胞间变性变常不明显,较容易见胞核假包含体(“甜甜圈”细胞)。
免疫表型:与 ALK+ ALCL 相似,但不表达 ALK,T 细胞相关抗原表达率较高,EMA 表达率较低。CD30 均匀一致强阳性(胞膜和高尔基区),CD43+,TIA1+/-,粒酶+/-,穿孔素+/-,CD4+/-,CD3+/-,CD2+/-,EMA-/+(43%+),LMP-1-, EBER-。需注意的是,有 DUSP-IRF4 易位的病例上述 T 和细胞毒标记常阴性。部分病例表达核磷酸 STAT3。
TCR 基因克隆性重排。约 30%病例有 DUSP 重排或 DUSP-IRF4 易位,8%病例有 TP63 重排。部分病例有 STAT3 基因突变。

免疫组织化学染色:
与 ALK+ ALCL 相似,但不表达 ALK,T 细胞相关抗原表达率较高,EMA 表达率较低。CD30 均匀一致强阳性(胞膜和高尔基区),TIA1+/-,粒酶+/-,穿孔素+/-,CD4+/-,CD3+/-,CD2+/-,EMA-/+,LMP-1-, EBER-
鉴别诊断:
- 转移瘤 :转移瘤可呈现窦内寝润,有的表达 EMA(癌)或 CD30(胚胎性癌),易与 ALCL 混淆。但转移瘤同时表达别的有关抗体(如 CK,OCT3/4)。
- 外周 T 细胞淋巴瘤,非特指 (PTCL,NOS):细胞通常不具间变性,也很少窦内浸润。 虽有的病例 CD30 阳性,但一般较弱,强弱不均或局灶阳性。有的病例,鉴别二者很困难。
- 间变性大细胞淋巴瘤,ALK 阳性 (ALCL,ALK+):形态学和免疫学与 ALCL,ALK-相似,但表达 ALK。预后较好,生物学上两者应属不同实体。
- 经典型霍奇金淋巴瘤 (CHL):ALK- ALCL 需与 CHL(特别是合胞体变异型)相鉴别。CHL 中的 HRS 细胞 CD30 +、CD15+/-、PAX5+、CD20-/+、 EMA-。
- 原发性皮肤 ALCL :常表现为单个皮肤结节或肿块伴溃疡。形态学和免疫学与系统性 ALCL 相似,需除外系统性 ALK- ALCL 累及皮肤,要结合临床加以鉴别。
预后:
预后总体比 ALK+ ALCL 差,但较 PTCL-NOS 好。有 TP63 重排预后不良。
